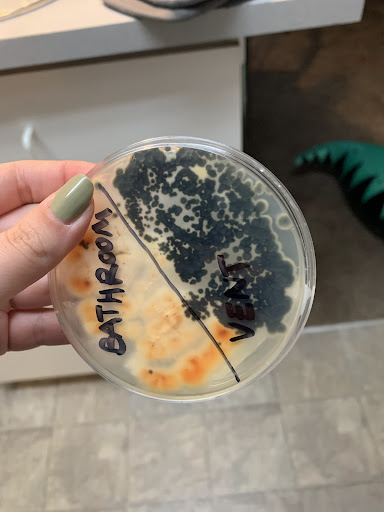

The Monroe Apartments things to do, attractions, restaurants, events info and trip planning

Basic Info
The Monroe Apartments
1150 S Clarizz Blvd, Bloomington, IN 47401
3.7(387)
Closed
Save
spot
spot
Ratings & Description
Info
attractions: Latimer Woods, restaurants: Toto's Uncle Cafe, Bangkok Thai Cuisine, Truffles Fine Cuisine & 56 Degrees Bar, Sunny Palace, Crumbl, Zero Degrees, Hoosier Hank's (East), Five Guys, Sakura 15, Kroger Bakery, local businesses: Hobby Lobby, Kroger, Xfinity Store by Comcast, Plato's Closet Bloomington, B-Town International Market, Bloomington Hardware, Curry Auto Center, Habitat For Humanity ReStore, uBreakiFix - Phone and Computer Repair, Game World
 Learn more insights from Wanderboat AI.
Learn more insights from Wanderboat AI.Phone
(833) 400-6967
Website
themonroeliving.com
Open hoursSee all hours
Thu10 AM - 6 PMClosed
Plan your stay

Pet-friendly Hotels in Bloomington
Find a cozy hotel nearby and make it a full experience.

Affordable Hotels in Bloomington
Find a cozy hotel nearby and make it a full experience.

The Coolest Hotels You Haven't Heard Of (Yet)
Find a cozy hotel nearby and make it a full experience.

Trending Stays Worth the Hype in Bloomington
Find a cozy hotel nearby and make it a full experience.
Reviews
Live events

Bloomington Murder Mystery: Solve the case!
Sun, Feb 1 • 12:00 AM
601 E Kirkwood Ave, Bloomington, IN 47405, USA, 47405
View details

Mariachi Herencia De Mexico
Fri, Feb 20 • 12:30 AM
Indiana University Auditorium, 1211 East 7th Street, Bloomington, IN 47405, US, United States
View details

Vienna Teng performs live in Bloomington, IN
Fri, Feb 20 • 7:00 PM
Buskirk-Chumley Theater, 114 E Kirkwood Ave,Bloomington, Indiana, United States
View details
Nearby attractions of The Monroe Apartments
Latimer Woods

Latimer Woods
4.1
(24)
Closed
Click for details
Nearby restaurants of The Monroe Apartments
Toto's Uncle Cafe
Bangkok Thai Cuisine
Truffles Fine Cuisine & 56 Degrees Bar
Sunny Palace
Crumbl
Zero Degrees
Hoosier Hank's (East)
Five Guys
Sakura 15
Kroger Bakery

Toto's Uncle Cafe
4.5
(155)
$
Click for details

Bangkok Thai Cuisine
4.4
(247)
$
Closed
Click for details

Truffles Fine Cuisine & 56 Degrees Bar
4.1
(143)
$$$
Closed
Click for details

Sunny Palace
4.2
(122)
$
Closed
Click for details
Nearby local services of The Monroe Apartments
Hobby Lobby
Kroger
Xfinity Store by Comcast
Plato's Closet Bloomington
B-Town International Market
Bloomington Hardware
Curry Auto Center
Habitat For Humanity ReStore
uBreakiFix - Phone and Computer Repair
Game World

Hobby Lobby
4.4
(671)
Click for details

Kroger
4.2
(483)
Click for details

Xfinity Store by Comcast
3.1
(307)
Click for details

Plato's Closet Bloomington
3.6
(137)
Click for details